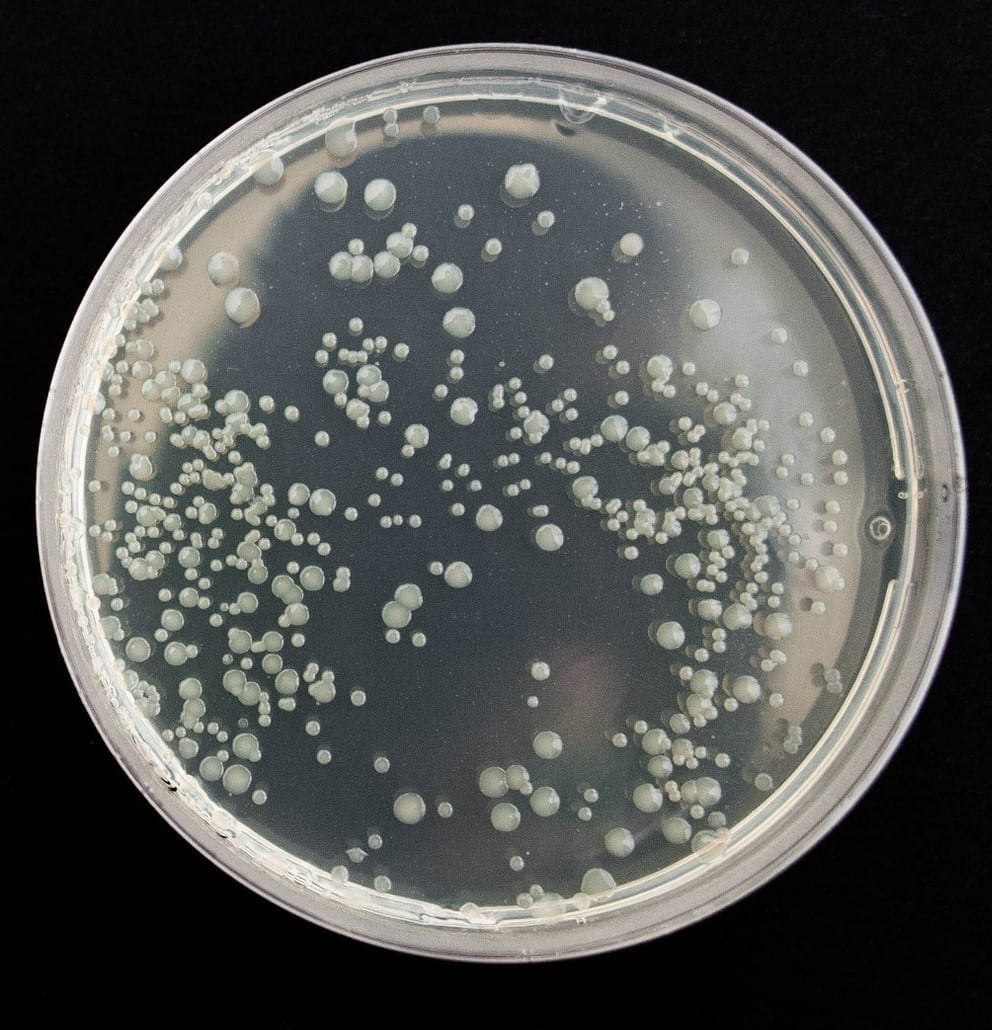

Sädesienitesti on helppo ja luotettava tapa tunnistaa sisäilmaongelmia jo varhaisessa vaiheessa.
TSA sädesieni- ja bakteeritesti on pintanäytteeseen perustuva tee se itse ratkaisu, joka paljastaa piilevät mikrobit, kuten sädesienet ja bakteerit, suoraan kodin tai työpaikan pinnoilta. Näkyvät tulokset saat muutamassa päivässä.
Miksi sädesienet kannattaa havaita ajoissa?
Sädesienet ovat erityisiä bakteereita, jotka viihtyvät kosteissa rakenteissa ja voivat aiheuttaa hengitysoireita, väsymystä, ihoärsytystä ja yleistä huonovointisuutta. Ne eivät näy paljaalla silmällä, mutta voivat vaikuttaa merkittävästi sisäilman laatuun ja terveyteesi. Ajoissa tehty sädesienitesti voi säästää suuremmilta ongelmilta.
Kehitetty Tanskan teknologisessa instituutissa – tarkkaa testausta kotona
TSA testi (Tryptic Soy Agar) on kehitetty Tanskan teknologisessa instituutissa ja suunniteltu erityisesti sisäpintojen mikrobien, kuten sädesienten ja bakteerien, havaitsemiseen. Se täydentää loistavasti V8 hometestiä, sillä TSA tunnistaa myös Gram positiiviset ja Gram negatiiviset bakteerit. Näin testaus kattaa entistä laajemmin sisätilojen mikrobit.
???? Testiä voi käyttää myös siivouksen laadun tarkkailuun. Liiallinen bakteerikasvusto kertoo, että pinnoilla on jäämiä, jotka voivat edistää mikrobien kasvua.
Näin sädesienitesti toimii
Avaa petrimaljan kansi (geelipinta on kannessa)
Paina geeliä kevyesti testattavaan pintaan, yksi painallus per malja
Merkitse paikka, aika ja mahdollinen näytenumero etikettiin
Sulje malja ja säilytä sitä huoneenlämmössä varjoisassa paikassa
Tarkkaile kasvustoa 4–8 päivän ajan. Tulokset näkyvät silmämääräisesti värikkäinä pesäkkeinä
Märkätiloissa 3–5 pesäkettä voi olla normaalia, kun taas kuivissa tiloissa pesäkkeitä esiintyy tyypillisesti 1–2. Mikäli tuloksia tulee enemmän, suosittelemme lisätutkimuksia. Näyte voidaan toimittaa laboratorioon mikrobien tarkempaa tunnistusta varten jopa kahden viikon sisällä näytteenotosta. Laboratoriotutkimuksen voit tilata helposti osoitteesta:
https://testeri.xf.fi/tuote/tsa-naytteen-laboratorioanalyysi/
Kenelle sädesienitesti sopii
• Asuntojen ostajat ja myyjät
• Remontin tai sisäilmakorjauksen suunnittelijat
• Henkilöt, joilla esiintyy sisäilmaoireita
• Työpaikat, päiväkodit ja oppilaitokset
• Siivouksen tason tarkistamiseen
Miksi valita TSA sädesienitesti
• Tulokset näkyvissä muutamassa päivässä
• Soveltuu bakteerien ja sädesienten tunnistamiseen
• Täydentää V8 hometestiä
• Käytettävissä useissa eri tiloissa
• Hyödyllinen myös siivouslaadun seurannassa
???? Vinkki
Tee testi useammassa kohdassa esimerkiksi eri huoneista ja vertaa tuloksia. Näin saat kattavamman kuvan tilojen kunnosta.
Sädesienitesti auttaa sinua toimimaan ennen kuin sisäilmaongelmat pahenevat.
Helppokäyttöinen, nopea ja luotettava testi, joka tuo mielenrauhaa ja suojaa terveyttä.